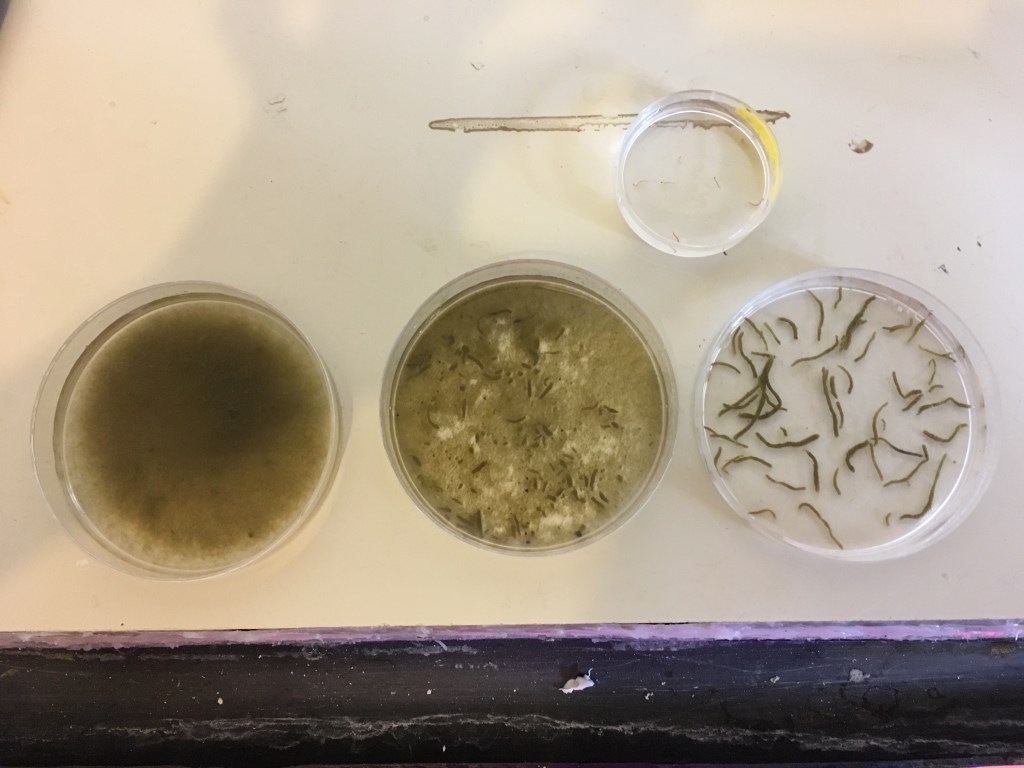

Studying the ecology of Lake Mývatn in Iceland
I was extremely lucky to spend the summer of 2017 as a research intern studying the ecology of Lake Mývatn in northeast Iceland. The scenery in Iceland is incredible and Lake Mývatn is particularly special. Every spring/summer thousands of midges emerge from the lake and in doing so transport nutrients from the lake to the land, essentially fertilising lakeside vegetation and altering the surrounding terrestrial ecosystem. However, there are huge, and seemingly unpredictable, fluctuations in the numbers of midges that emerge each year. Over a decade the midge population can fluctuate by up to 5 orders of magnitude and researchers from the University of Wisconsin-Madison and Lake Mývatn Research Station are trying to understand why.
The fieldwork we conducted that summer was split into two main themes: sampling the lake and sampling the land. In the lake we took sediment cores to identify, count and measure midge larvae as well as several different water samples for zooplankton counts and chlorophyll quantification. Sampling the terrestrial food web was mainly carried out with sticky cards and infall traps for adult midges, and pitfall traps for arthropods. With having 24 hours of daylight and an immense amount of fieldwork to get done, we spent some pretty long days out on the lake and in the lab, but I wouldn’t change it for the world. I am eternally grateful to Professor Tony Ives for giving me this wonderful opportunity and to the research students and other interns who made the summer unforgettable in all the right ways. Here’s a few photos of the research and the incredible Lake Mývatn:
My Project
Alongside the routine monitoring of the lake, we got to conduct our own smaller research projects, and I wanted to investigate factors that could cause fluctuations in the numbers of midges emerging from the lake.
The species that dominates the lake sediments is a Chironomid midge, Tanytarsus gracilentus. T. gracilentus are obligate tube-builders, meaning they construct and live within silk tubes at the sediment surface. Lake Mývatn is a shallow lake so wind-driven disruption to the sediment is common. My thinking was that tube-building is likely a costly activity for midges so any disruption to the sediment, which could result in midges having to rebuild their tubes, could affect resource allocation, thus slowing growth and emergence rates. So, I designed an experiment to investigate the effects of tube re-building under different environmental conditions on T. gracilentus development.
I stocked 72 microcosms with 20 larvae from the lake and exposed them to differing levels of disturbance resulting in larvae having to rebuild their tubes from one of: 1) sediment containing the original intact tubes; 2) sediment containing the original crushed tubes; or 3) fresh sediment containing no tubes. Each tube re-building treatment was crossed with additions of nitrogen (N) or phosphorus (P), and exposure to two shading levels (light/dark).
The experiment ran until the midges started to emerge from the tubes, at which point we had to put little mesh ‘hats’ over the top so that we could capture the adult midges. The emergence ran for 2 weeks, every day of which we extracted adult midges from each of 72 tubes. The relative size of the adults was approximated by measuring their wing lengths, and the survival and emergence rates were also calculated at the end of the experiment.
I expected that larvae having to re-build tubes from fresh sediment or sediment containing crushed tubes would be less likely to emerge as adult midges, and those that did would be smaller than the emerging adult midges that rebuilt tubes from sediment containing intact tubes. As nutrients and light can increase resource availability, I suspected that costs incurred from tube re-building might be offset by the addition of N, P and light, therefore dampening any differences in adult emergence rates and sizes. We’re still working on publishing the results so you’ll have to wait and see for detailed findings!









